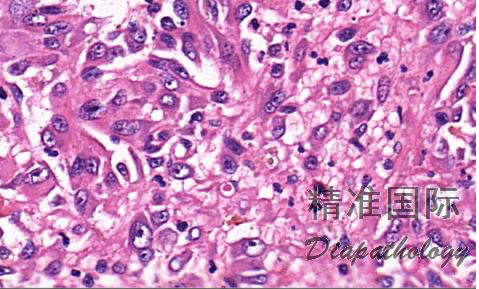
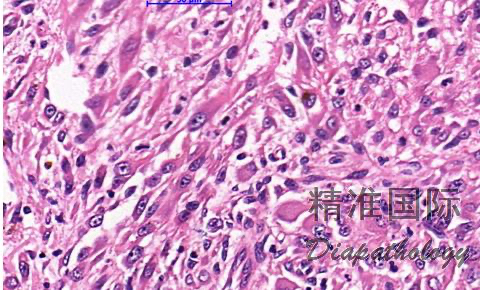
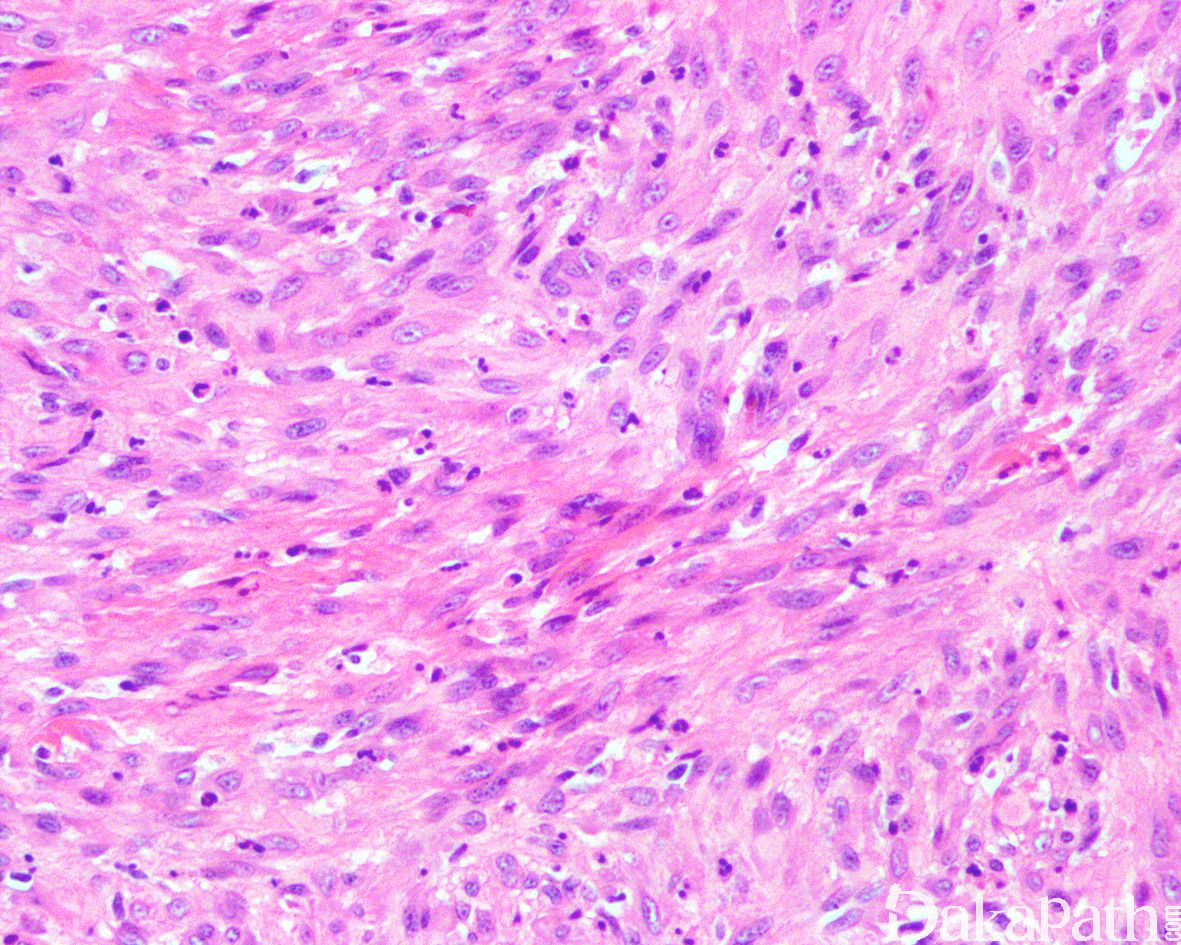
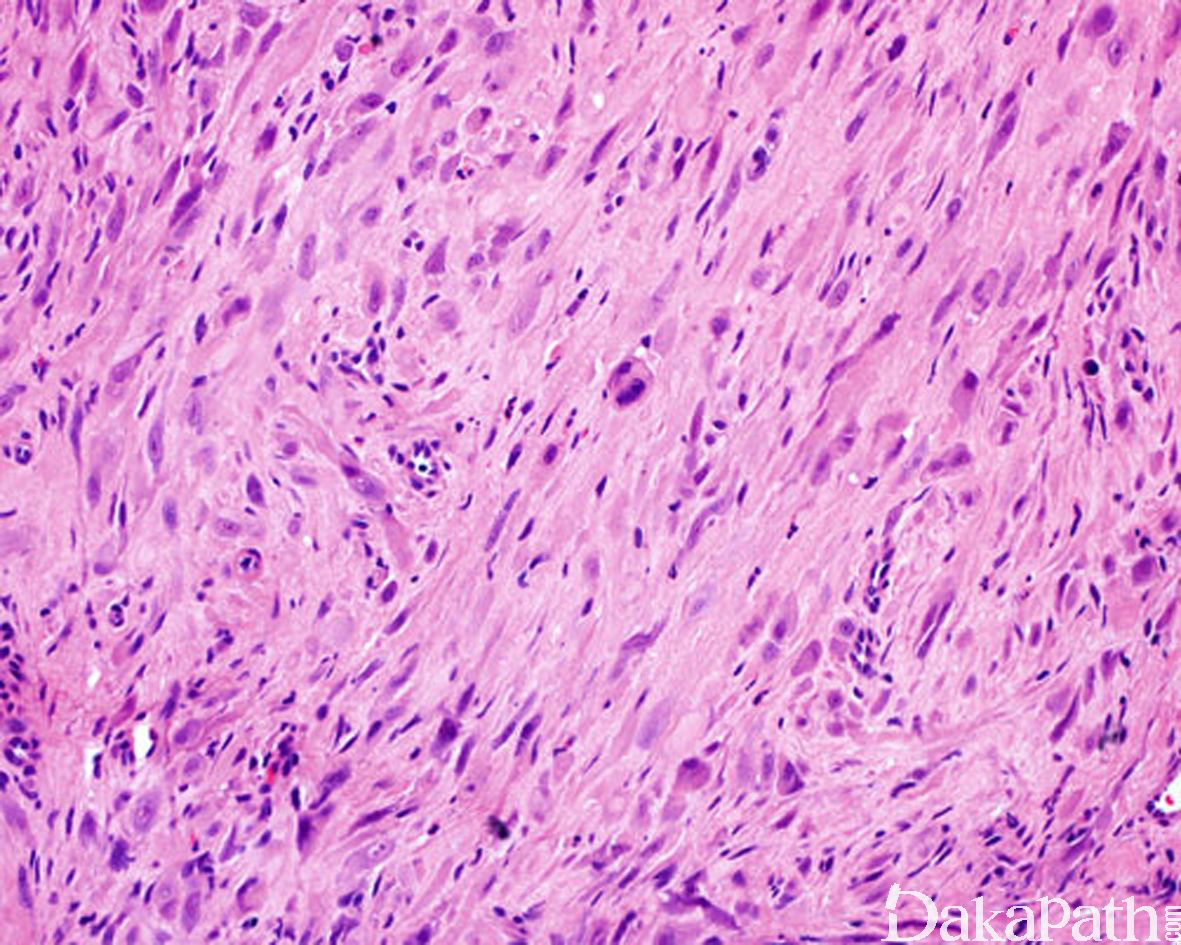
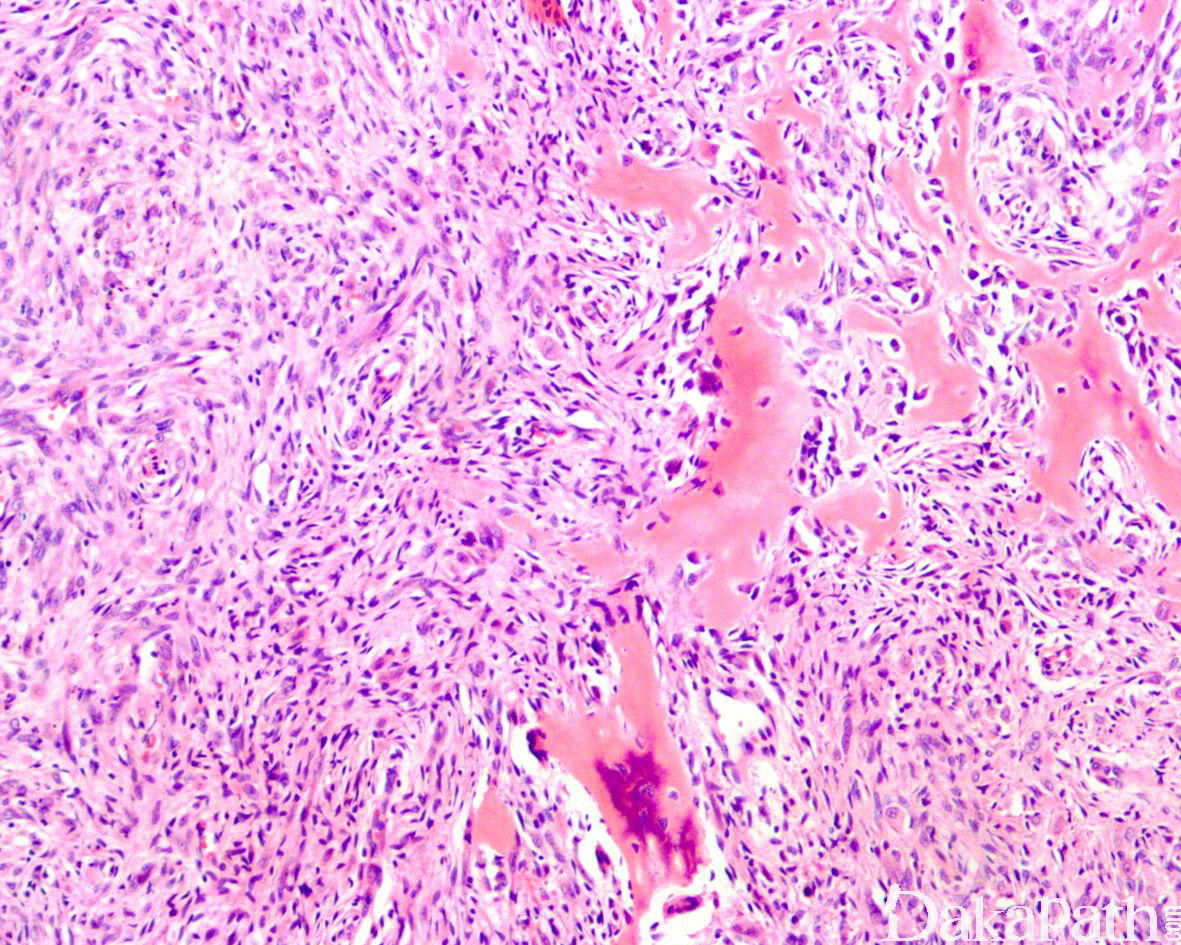

假肌源性血管内皮细胞瘤
pseudomyogenic hemangioenothelioma
同义词(或曾用名): 上皮样肉瘤样血管内皮细胞瘤
概述:
是一种组织学上具有肌源性丰富的胞浆和梭形细胞特征的中间型血管内皮细胞肿瘤,
发病部位: 四肢,以下肢为多见,也可见于躯干、肢带和头颈部
诊断要点:
好发于年轻成人(平均年龄 30 岁,80%以上年龄在 40 岁以下),男性多见(男/女:5:1);
多见于下肢,上肢、躯干、头部较少见; 3.66%多灶发生,累及多个组织平面(从真皮层到骨均可累及),平均直径约 1.9cm;肿瘤呈灰白结节状或界限不清的肿块,有时可伴坏死,累及皮肤时可伴溃疡;
肿瘤细胞呈密集片状或不规则束状或丛状排列浸润至皮下脂肪组织和肌肉组织内;
瘤细胞胖梭形,部分呈上皮样,具丰富的嗜酸性胞质;
上皮样细胞可呈上皮样肉瘤样细胞或横纹肌母细胞样;
无明显血管腔或出血,偶见局部的胞浆空泡提示血管内皮细胞分化;
瘤细胞多形性不明显,核空泡状,具小核仁,核分裂像少见,通常少于 2/10HPF;
少数病例可显示明显核异型、核分裂增多;
背景中可见弥漫散在的中性粒细胞浸润,极少数可见液化性坏死,通常无上皮样肉瘤可见的地图状肿瘤性坏死;
部分可见血管浸润和神经累犯;
发生于骨内者可见较多的破骨巨细胞聚集。

免疫组织化学染色:
肿瘤细胞恒定表达 FOSB、AE1/AE3. ERG、FLI-1. INI1,CD31 表达不一,较少表达 EMA,部分表达 SMA,而 CD34. Desmin、MyoD1. S100 阴性,INI-1 无表达缺失
分子标记:
SERPINE1-FOSB 基因融合和 ACTB-FOSB 基因融合
鉴别诊断:
上皮样血管内皮细胞瘤 :典型地表现为微小梁状结构,伴灶状原始血管腔形成,位于软骨黏液性基质之内,弥漫表达 CD31 和 CD34,CAMTA1 基因融合。
上** **皮样血管肉瘤:细胞异型明显,核仁突出,核分裂像易见。
上皮样肉瘤:INI1 表达缺失;
上皮样血管瘤:通常界限较清楚,无浸润性生长,瘤细胞上皮样为主,呈实性巢状或两者排列,无明显管腔形成。
治疗:
局部广泛切除,部分可能需要截肢,复发的病例可采用局部放疗
参考文献:
Walther C, et al. J Pathol. 2014;232: 534–540. Huang SC, Am J Surg Pathol. 2015; 39: 1313–1321. Hornick HL, Fletcher CDM. Am J Surg Pathol 2011,35:190–201
← 复合性血管内皮细瘤 上皮样血管内皮细胞瘤 →
